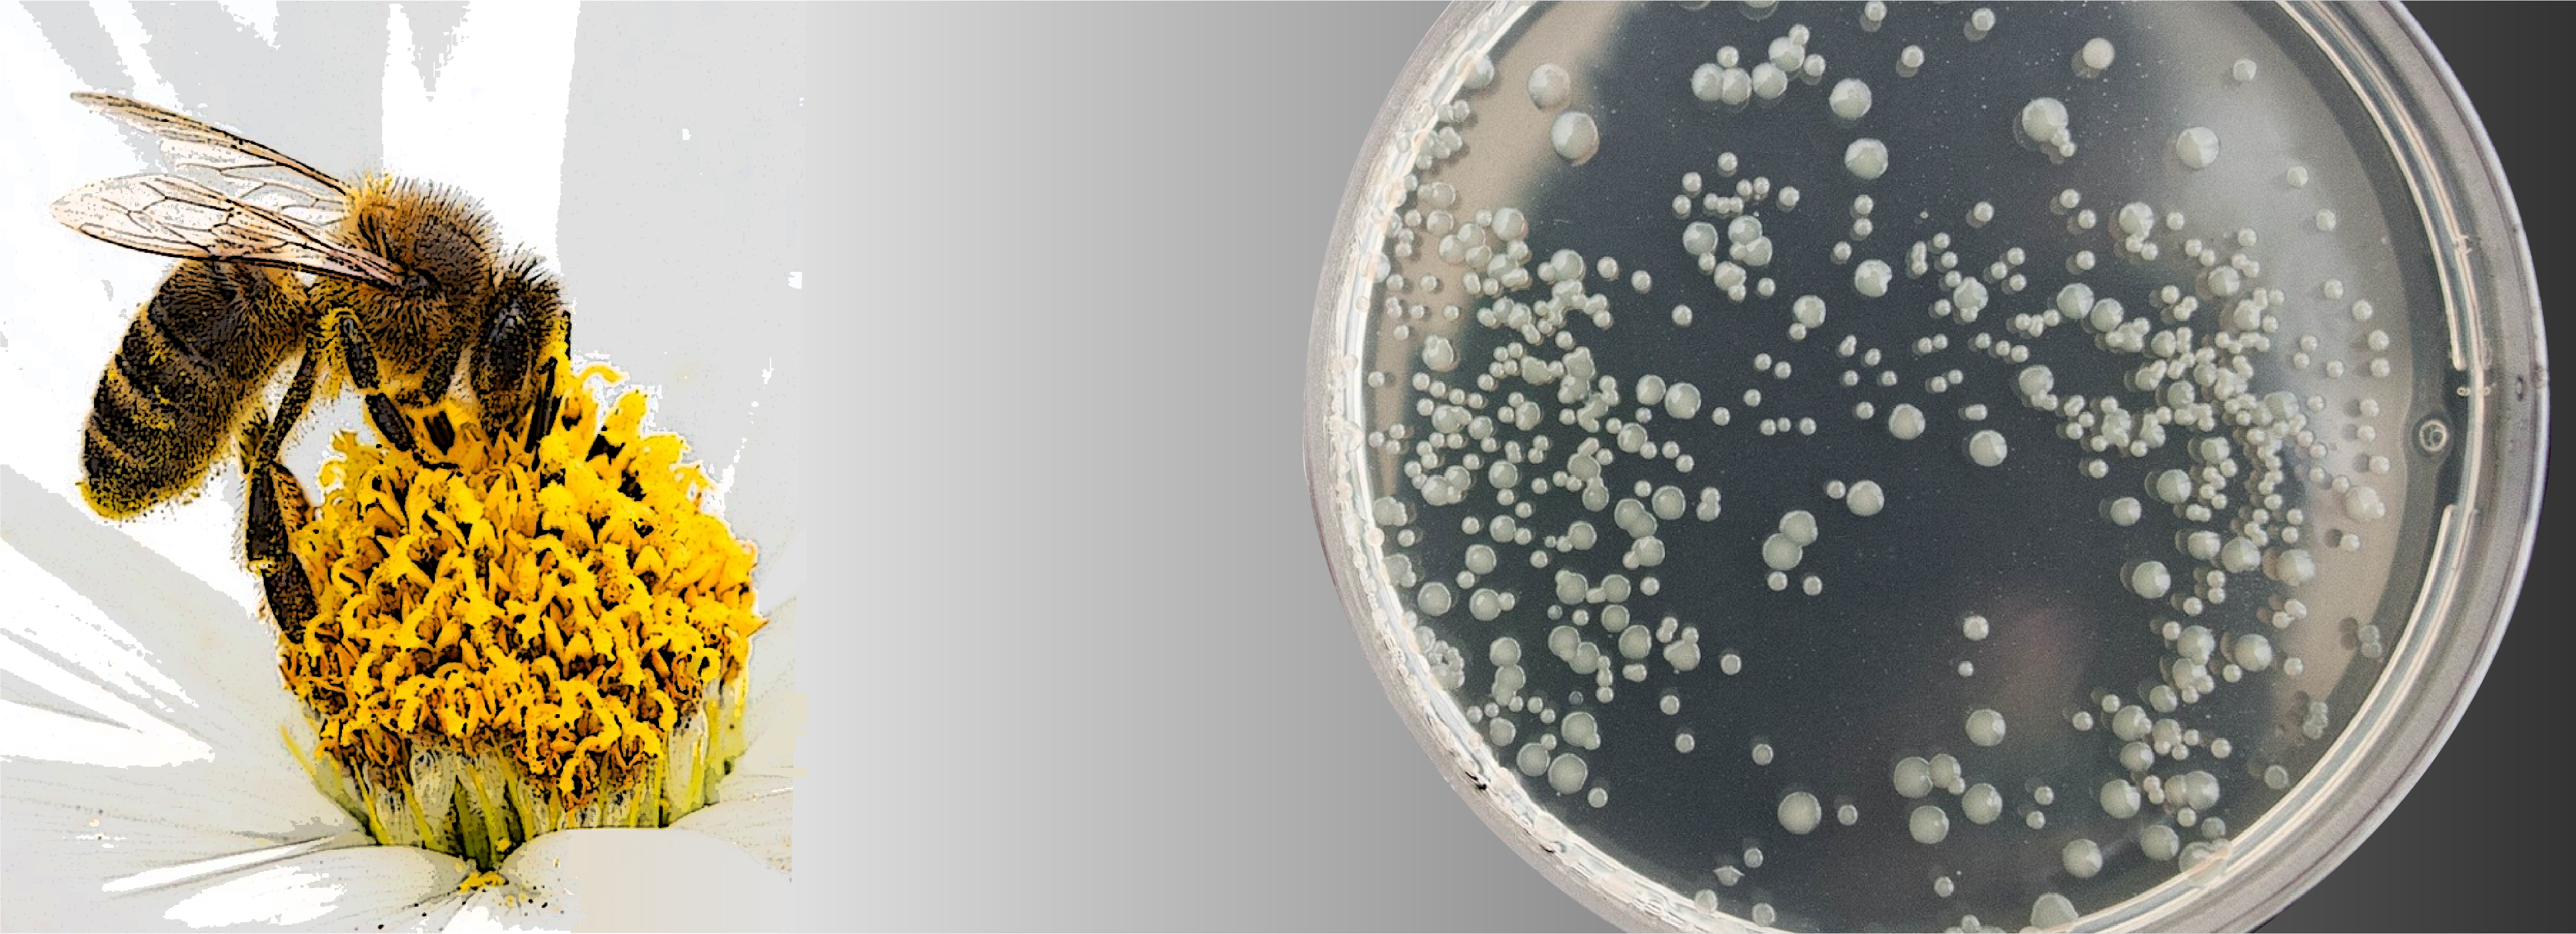
bacteria growing on petri dish

Evolution of symbiosis, insects and microbes SYMPOSIUM
The University of Texas at Austin
March 29, 2025
8:30 am - 5:00 pm
The last 3 decades have seen a dramatic increase in understanding of how symbiotic interactions have shaped the evolution of life from its earliest stages. Much of this increase is due to novel methods in genomics and related technologies. But progress can also be traced to the diversity of approaches adopted by the symbiosis research community, including field studies, development of experimental laboratory models, and advanced microscopy methods.
This interdisciplinary symposium will span topics related to animal-microbe symbiosis and its consequences for evolution of both host and symbiont. Most talks will be given by former members of the laboratories of Nancy Moran or Howard Ochman, now in institutions around the US and in Europe and Asia. The symposium will allow ample time for discussion, potentially enabling participants to initiate new collaborations.

Program
evolution in gut microbiomes, translation in endosymbionts, predatory amoeba, symbiont-mediated evolution of haplodiploidy, sRNAs in bacteria, beneficial viruses of parasitoid wasps, defensive symbiosis in insects, sociality and symbiont gain and loss, symbionts and detoxification, metagenomic datasets, mobile genetic elements in guts, genetic drift in microbiota, bacteriophage in marine Archaea, the oral microbiome, symbionts of insect gall-formers, chromosome evolution and more

Travel
The symposium wiill be held on the University of Texas at Austin campus in the Moffett Molecular Biology (MBB) building on March 29, 2025. Austin-Bergstrom International Airport (AUS) is the nearest airport. There are two campus adjacent hotels: The Austin Moxy is about a 10 minute walk from the symposium building and The AT&T Hotel and Conference Center is about a 16 minute walk from the symposium building.